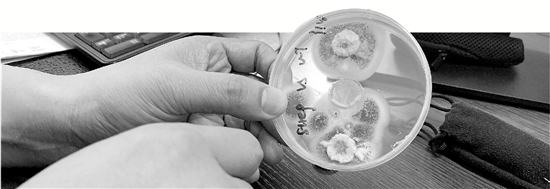

方卫国实验室培养的绿僵菌。
因为一种名为“耳念珠菌”的多重耐药性真菌在美国多地爆发,超级真菌的概念进入公众视野,连股市都受到影响,病毒防治板块一片飘红。其实耳念珠菌只是一种在医院里发展出来的真菌,一般不会往广泛大众群传播。
人们对真菌的了解,相对病毒、细菌,要少许多。在最近一期《美国科学院院报》杂志上,浙江大学生命科学学院方卫国教授团队发表了一项有趣的研究,他们分析了一种叫做“绿僵菌”的真菌基因,搞清楚了这种真菌为什么能够成功毒杀比它高级许多的生物——昆虫,而且还把每一只虫的尸体都给弄绿了。
别小看真菌的威力
最近有种真菌在美国多地爆发
地球上经常有新的病原菌出现。“比如SARS、埃博拉病毒,都是新出现的病原造成的疾病。”方卫国说,但是真菌病原,此前人们关注得相对比较少,因为真菌很少直接感染人类,“但其实真菌病原对粮食安全、生态环境,甚至人类健康,都会造成很大的影响。”
比如,新出现的小麦秆锈病菌Ug99菌株可使整片农田小麦颗粒无收。
“新的病原真菌的出现,对生物物种的多样性会有影响。”方卫国举例子讲,比如,青蛙会被灭种,蝙蝠鼻子会“长白毛”,也不能活了。
这几天大家密切关注的耳念珠菌,其实早在2009年,就有研究者在一名日本患者的外耳道分泌物中发现了它。
这是一种院内感染菌。“是在医院内获得的感染,一般发生在本身有基础疾病的人身上(尤其是抵抗力比较差的住院病人),正常人不易感染。”方卫国说。
所以,科学家需要去探索新的真菌病原出现的机制,以便人们做出预测和相应的预防。
方卫国课题组就选了一种昆虫病原真菌来做研究,它的全名叫“罗伯茨绿僵菌”。
为什么它跟大嘴美女朱丽叶·罗伯茨同姓?其实,这个罗伯茨,来自康奈尔大学的教授唐纳德·罗伯茨的名字,这位教授是方卫国的师爷爷(导师的导师),他对绿僵菌的研究,做出了巨大的贡献。
这个真菌名副其实:它是绿的。
待它长到孢子的状态时,细胞壁上会自带绿色素,这种绿色能帮助真菌抗逆,适应恶劣环境。如果它们去感染昆虫,那么昆虫会被它们给“绿”了。比如蟑螂、蚊子、蝗虫、大蜡螟……不管生前长啥样,死后都是绿油油的,让人瘆得慌,而且还会变成“僵尸”。
它是植物的铁哥们
是昆虫的头号杀手
别看罗伯茨绿僵菌是很多动物的头号杀号,但它却是植物的铁哥们,与植物互惠共生。
在自然界,罗伯茨绿僵菌保持种群的一种主要方式,是在植物根际与与植物共生。“通常,它们优先选择禾本科植物,比如很多种草。”
方卫国解释了真菌和植物兄弟是如何相互扶植的——
植物光合作用产生糖,一部分运送到根部,绿僵菌就能从植物根部那里得到生存所需的碳源;
一分恩惠,三分回报,绿僵菌能分泌小分子酸,把土壤中植物难以利用的磷溶解出来给植物利用,还能分泌植物生长激素,直接促进植物的生长;
绿僵菌还能够与侵害、感染植物的真菌、细菌斗争,感染来吃植物的害虫,是植物的天然杀虫剂;
所以,真菌简直是植物的生物肥料和生物杀虫剂么——多么和谐的一对。
可是,昆虫就没那么好运了,绿僵菌是很多昆虫的天敌。
昆虫的体壁,相当于人的皮肤+骨骼,是防止外来微生物的第一道障碍。而绿僵菌能够穿透它,以菌丝的形式穿透体壁后,进入昆虫的血腔。
进入血腔的真菌,马上会变形成酵母状的单个细胞。“这个体态,利于真菌在血液里快速游动,尽快占领整个血腔。”方卫国说,所以昆虫很快就会被真菌完全感染,败下阵来的虫子,在生死线上挣扎个大约两周,差不多就绿了。
2011年,方卫国团队在《科学》杂志上发表了一项研究成果,他们把传播疟疾的蚊子给绿了。
蚊子在叮咬疟疾病人后,疟原虫进入蚊子体内的血腔,大量繁殖,而当蚊子叮咬正常人时,它被蚊子连口水一并吐出来,进入人的体内。
是的,疟原虫和绿僵菌一样,都会进入到昆虫血腔,它们在血腔相遇了。
而方卫国的团队用了两种办法,让这场相遇变成致命邂逅。
一种方法,是让绿僵菌通过遗传改造,用蛋白把疟原虫直接干掉;另一种方法,相当于是给疟原虫关禁闭,阻止它进入蚊子的唾液腺,蚊子就算咬人,也只会致人发痒,不会被传染疾病。
这项技术,现在正在非洲疟疾高发的地域进行田间试验。
科学家拿它泡水喝
别怕,绿僵菌对人类无害
科学家发现,绿僵菌是在进化的过程中,获得了杀昆虫的能力。“物种所具有的某种功能,都是由基因控制的。”方卫国说,只有基因通过表达蛋白,才能帮助生物实现各种能力。
绿僵菌的一些关键杀虫力基因,是从别的生物身上“拿”来的。
方卫国说,生物获得基因有两种方式:通过祖先垂直遗传;基因水平转移——基因在亲缘关系很远的物种之间进行交流。
而绿僵菌获得的杀虫能力,就是来自这种远距离的亲缘关系。远到什么程度呢?“好比人从细菌身上,拿一个基因过来。”
怎么拿过来?这些基因有可能是随机整合进了绿僵菌的基因组,由于它们能帮助绿僵菌更好适应环境,而被留在了基因组里。比如方卫国团队就发现,在罗伯茨绿僵菌全身共有的1.1万个基因里头,有18个基因,是从其他物种那里获得的。
他们仔细地分析了这18个基因。
“其中2/3的基因,碰到昆虫体壁的时候,表达量非常高。也就是说,是它们在帮助绿僵菌穿透昆虫体壁。还有1个基因,对绿僵菌定殖昆虫血腔,起关键作用。”方卫国说。
还有5个基因,是目前不同种的绿僵菌都存在的。科学家把这5个基因突变失活后,绿僵菌失去杀虫能力,对昆虫的致死率降到只有0.9%。
当然,我们不用怕,这种绿色的真菌对人都是无害的,就算不小心吃到肚子里,也被我们的胃消化掉了。
这件事情,有一位中国科学家亲身测试过了——他拿绿僵菌的孢子泡水,也就是说,他把绿僵菌当成绿茶喝了。
“一点都不好喝。不过,这是想要证明它对人非常安全。”
来源:钱江晚报 编辑:王育昕










